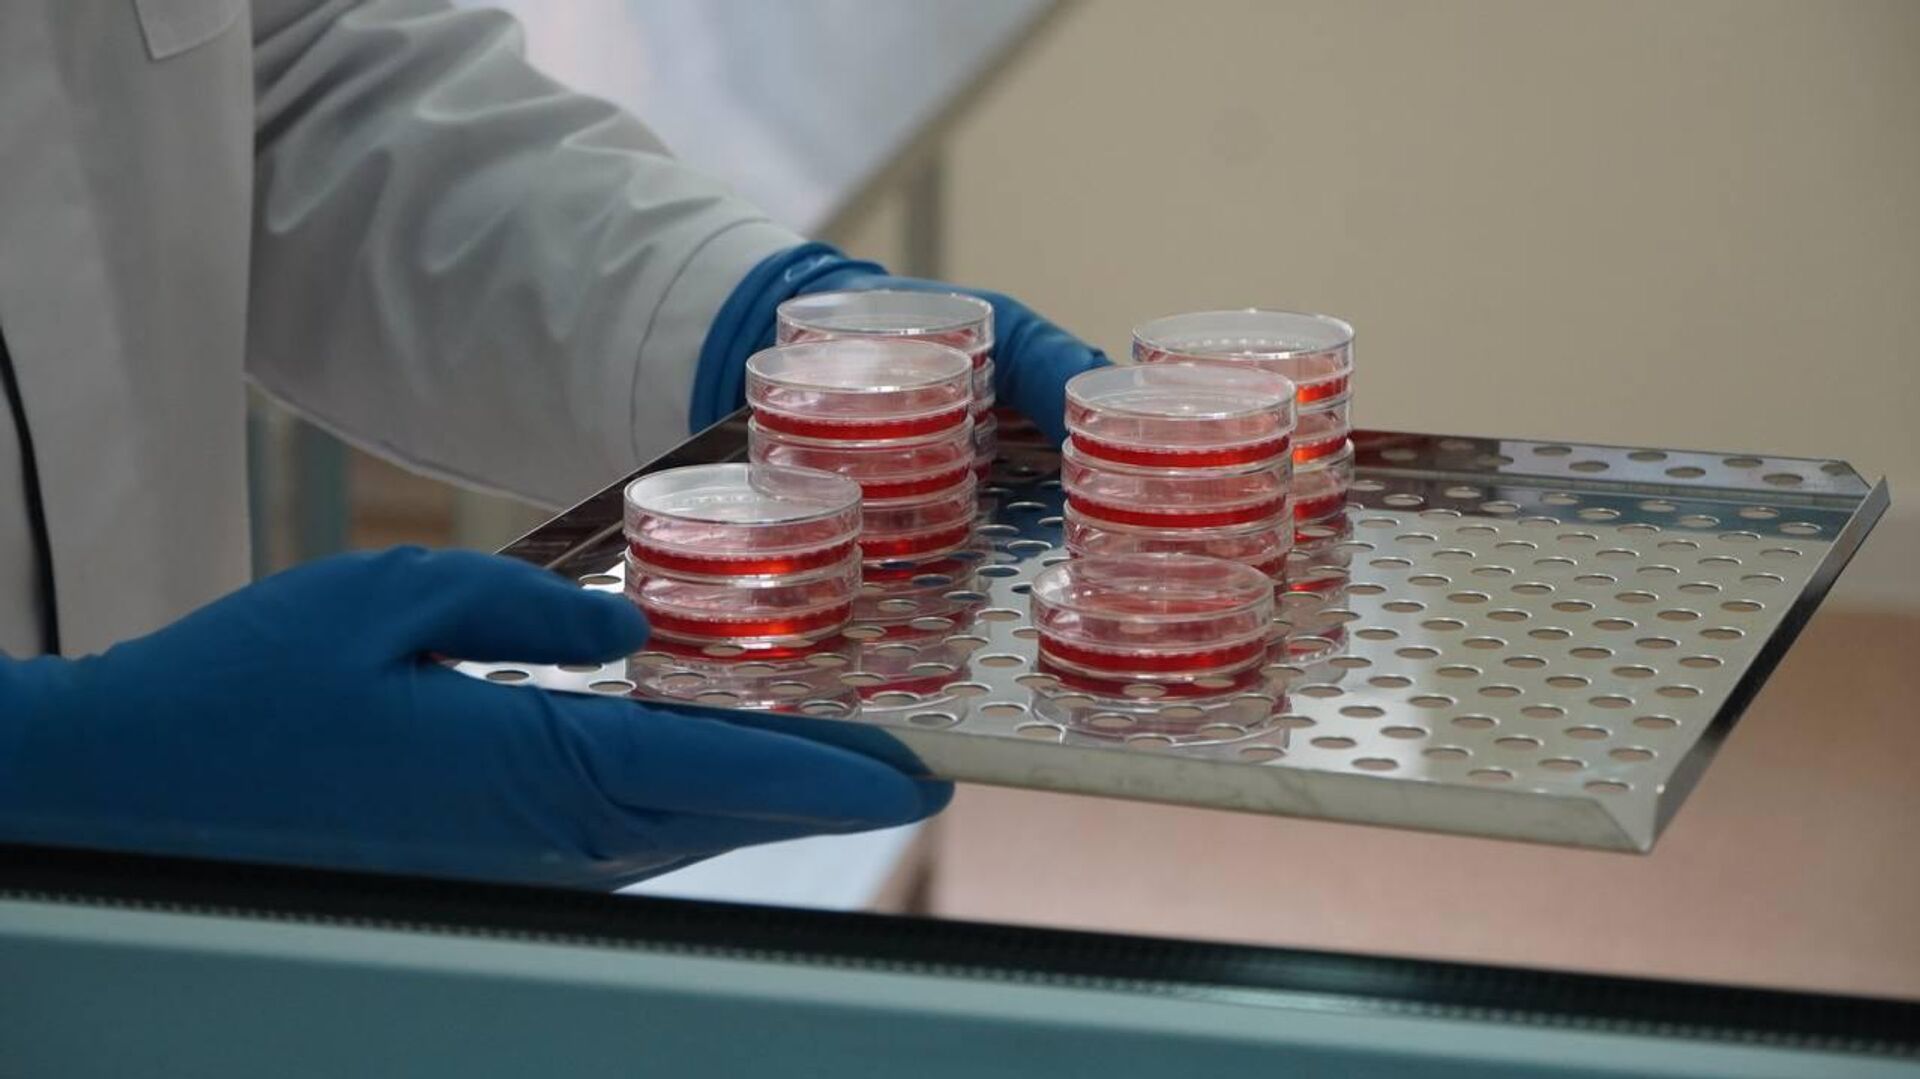
Лаборатория в СОГУ - Sputnik Южная Осетия, 1920, 08.02.2026

https://sputnik-ossetia.ru/20260208/strategicheskiy-shag-v-sogu-zapustili-laboratoriyu-po-issledovaniyu-kletok-37250946.html
Стратегический шаг: в СОГУ запустили лабораторию по исследованию клеток
Стратегический шаг: в СОГУ запустили лабораторию по исследованию клеток
Sputnik Южная Осетия
ЦХИНВАЛ, 8 фев – Sputnik. В Северо-Осетинском государственном университете имени К.Л. Хетагурова начала работу лаборатория клеточных технологий... 08.02.2026, Sputnik Южная Осетия
2026-02-08T19:39+0300
2026-02-08T19:39+0300
2026-02-09T09:13+0300
согу
северная осетия
новости
россия
наука
https://cdnn1.img.sputnik-ossetia.ru/img/07ea/02/08/37251662_0:0:1280:720_1920x0_80_0_0_6fa30d5c7dbb2e1a0ca0adb4d9695ecf.jpg
ЦХИНВАЛ, 8 фев – Sputnik. В Северо-Осетинском государственном университете имени К.Л. Хетагурова начала работу лаборатория клеточных технологий, ориентированная на проведение фундаментальных и поисковых исследований в области клеточной и молекулярной биологии. Об этом сообщает тг-канал СОГУ.Лаборатория оснащена современным высокоточным оборудованием, предназначенным для работы с культурами клеток человека и животных. Это создает условия для проведения междисциплинарных исследований в сфере биомедицины, включая иммунологию, микробиологию и ряд смежных научных направлений.Ректор СОГУ Алан Огоев подчеркнул, что серьезное обновление материально-технической базы и закупка современного высокоточного оборудования университетом проводились целенаправленно для того, чтобы обеспечить соответствие лаборатории международным стандартам, предъявляемым к современным научным центрам.На базе лаборатории уже ведутся активные научные исследования, направленные на разработку новых подходов к лечению и профилактике социально значимых заболеваний.
https://sputnik-ossetia.ru/20260130/uchenye-sogu-nashli-unikalnye-istochniki-s-margantsem-37120067.html
россия
Sputnik Южная Осетия
media@sputniknews.com
+74956456601
MIA „Rossiya Segodnya“
2026
Sputnik Южная Осетия
media@sputniknews.com
+74956456601
MIA „Rossiya Segodnya“
Новости
ru_OS
Sputnik Южная Осетия
media@sputniknews.com
+74956456601
MIA „Rossiya Segodnya“
Sputnik Южная Осетия
media@sputniknews.com
+74956456601
MIA „Rossiya Segodnya“
согу, северная осетия, новости, россия, наука
согу, северная осетия, новости, россия, наука
Стратегический шаг: в СОГУ запустили лабораторию по исследованию клеток
19:39 08.02.2026 (обновлено: 09:13 09.02.2026) ЦХИНВАЛ, 8 фев – Sputnik. В Северо-Осетинском государственном университете имени К.Л. Хетагурова начала работу лаборатория клеточных технологий, ориентированная на проведение фундаментальных и поисковых исследований в области клеточной и молекулярной биологии. Об этом сообщает тг-канал
СОГУ. Лаборатория оснащена современным высокоточным оборудованием, предназначенным для работы с культурами клеток человека и животных. Это создает условия для проведения междисциплинарных исследований в сфере биомедицины, включая иммунологию, микробиологию и ряд смежных научных направлений.
Ректор СОГУ Алан Огоев подчеркнул, что серьезное обновление материально-технической базы и закупка современного высокоточного оборудования университетом проводились целенаправленно для того, чтобы обеспечить соответствие лаборатории международным стандартам, предъявляемым к современным научным центрам.
"Для нас было принципиально важно, чтобы лаборатория клеточных технологий в СОГУ соответствовала всем мировым стандартам и требованиям к проведению биомедицинских исследований. Это позволяет нашим ученым работать на одном уровне с ведущими научными центрами и реализовывать проекты, имеющие реальное значение для медицины и общества", — отметил он.
На базе лаборатории уже ведутся активные научные исследования, направленные на разработку новых подходов к лечению и профилактике социально значимых заболеваний.